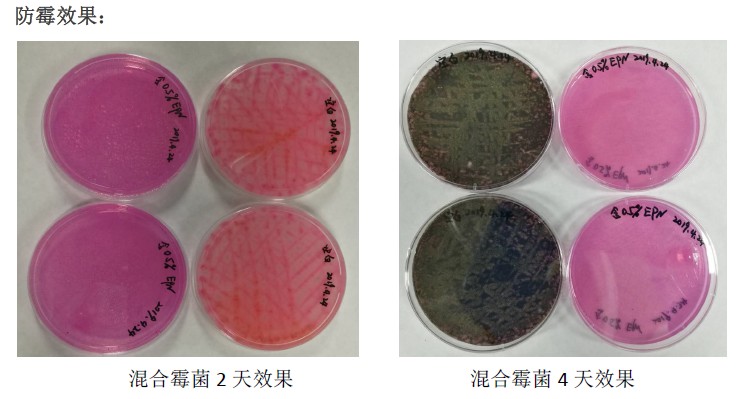

佛山市麗源化工有限公司
手機(jī):13686588876
電話:0757-82528560
郵箱:fslube@126.com
地址:廣東省佛山市南海區(qū)丹灶鎮(zhèn)建沙路建設(shè)開發(fā)區(qū)

首頁 > 應(yīng)用行業(yè)> 干膜防霉抗藻>

產(chǎn)品介紹: 麗源化工EPN是一種多用途廣譜經(jīng)濟(jì)有效的干膜保護(hù)殺菌劑,可抑制真菌在表面的生長繁殖。本產(chǎn)品是自由流動性的、水性的、0VOC分散體產(chǎn)品。麗源化工能為室內(nèi)各種應(yīng)用提供優(yōu)異的干膜保護(hù),...
麗源化工為您解決以下難題13686588876

防酸防臭
抑制,殺滅細(xì)菌、真菌、藻類等微生物,防止產(chǎn)品發(fā)酸發(fā)臭

防黃防黑
殺滅微生物,防止產(chǎn)品變黑或變黃,保證產(chǎn)品外觀

防腐防霉
防止產(chǎn)品腐爛、霉變,變質(zhì),確保產(chǎn)品品質(zhì)達(dá)標(biāo)

抗菌抑菌
殺滅細(xì)菌、真菌等微生物,防止細(xì)菌滋生
產(chǎn)品說明13686588876
| 外 觀 | 白色自由流動分散體 |
| 比重,20℃ | 約1.1 |
| 粘度,cps(20℃) | 2000-6000 |
| pH,20℃ | 約7 |
| 溶解性 | 幾乎不溶于水 |
| 運(yùn)用領(lǐng)域 | 建議使用濃度 |
| 油漆、涂料、水泥涂料 | 0.25-0.5% |
| 水性油墨 | 0.15-0.3% |
| 粘合劑和密封膠 | 0.1-0.3% |
| 根據(jù)歐盟規(guī)定,本產(chǎn)品在下面的使用量無需標(biāo)簽 | 0.66% |

聯(lián)系我們——免費(fèi)索取樣品13686588876